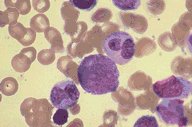

Description
In this low oil magnification Wright's stained bone
marrow aspirate, several myeloid precursors are
seen. An early promyelocyte is present in the
center and three metamyelocytes and a
segmented neutrophil surround it.
|
|
Click on this image
to enlarge it, then
on Back buttom
in the Netscape Menu
to shrink it back down



|